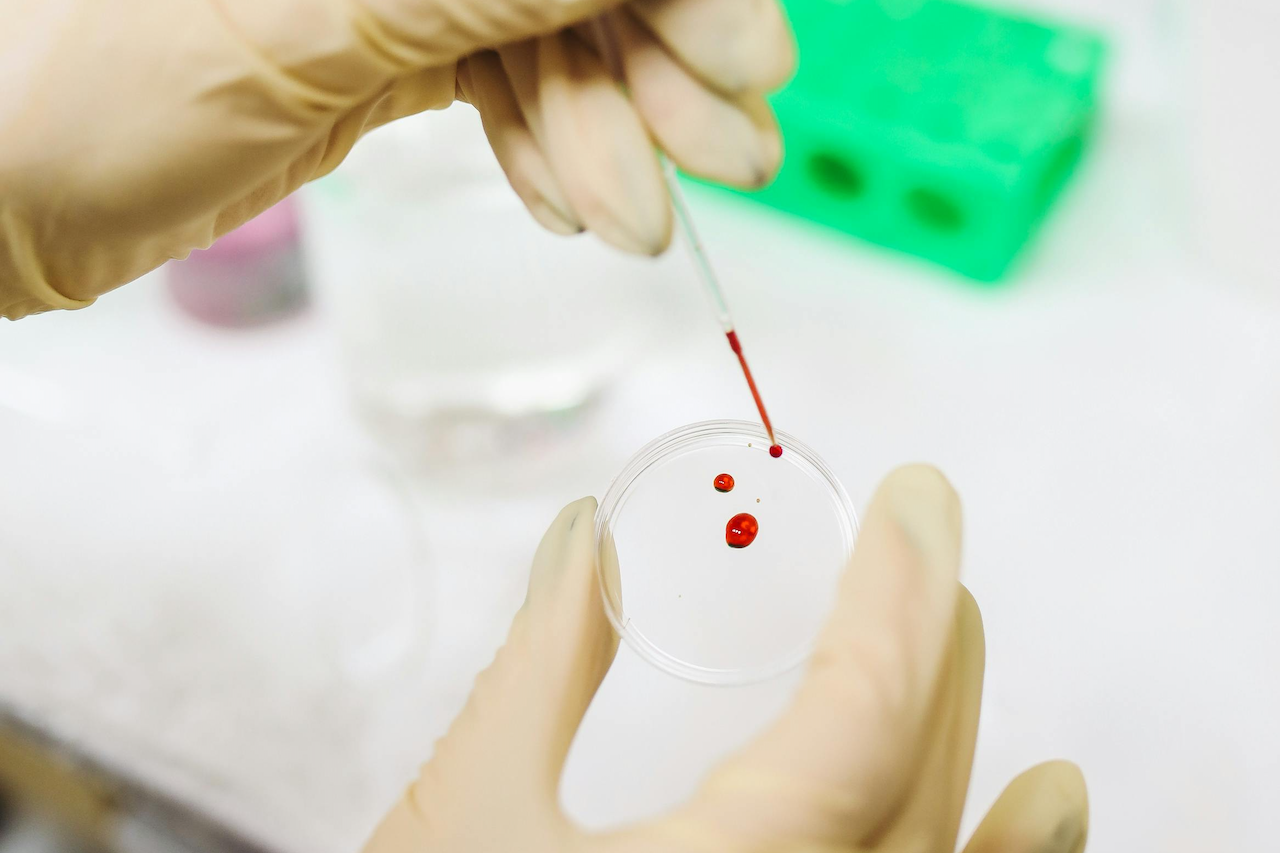
blood-test-lyme-disease-saunace blood-test-lyme-disease-saunace

Does infrared sauna help for Lyme, and truly help people with this disease? If you look at user reviews, you’d be inclined to say “yes.” Online there are many anecdotal success stories on how this form of heat therapy helps treat the chronic symptoms of Lyme disease.
But… the more we looked into scientific backing for this possibly beneficial connection, the more questions emerged. Peer-reviewed research into the claims is scarce and seems elusive. Our curiosity piqued.
In our research on infrared sauna therapy for Lyme, we found a recent study from 2020 [1] highlighting symptom similarities between Post-Treatment Lyme Disease (PTLD) and Chronic Fatigue Syndrome (CFS). CFS is characterized by persistent, unexplained fatigue. This parallel is encouraging when it comes to the use of infrared therapy, as it has proven effective for the relief of CFS symptoms.
An interesting intersection that we will cover later in more detail. In this blog post we share the findings of our quest, starting off with Lyme, a serious disease with 476,000 new cases every year [2].
A quick tour of the blog post
Lyme disease is caused by the bacteria Borrelia burgdorferi and sometimes Borrelia mayonii [3]. You contract these bacteria through the bites of infected ticks. The risk of contracting the disease is higher the longer a tick is attached.

Ticks belong to the family of arachnids and live on the blood of various hosts. These creatures cannot jump, but are adept at crawling onto their 'victim'. They wait in tall vegetation for passing animals or humans and then grab on with their feet to secure their next blood meal.
Because they live in grassy and wooded areas, children, especially kids between the ages of 5 and 14, and pets (mostly dogs) are more susceptible to Lyme disease.
The main vectors for Lyme disease are the black-legged tick, or deer tick, which is common in the northeastern, mid-Atlantic, and north-central United States, and the western black-legged tick, which is found mainly along the Pacific Ocean.
Not all ticks carry the Lyme disease bacteria; the likelihood of a tick being a carrier varies depending on factors such as geographic location and the tick's life stage.
While it is challenging to determine the exact percentage of ticks that are infected, the risk of encountering an infected tick is a lot higher in certain regions of the US.

A common misconception is that ticks perish or become inactive in cold weather. However, ticks can endure and remain dormant in lower temperatures, springing back into activity with warmer weather.
This adaptability renders Lyme disease a concern throughout the year in many areas, not just a seasonal hazard.
So, how do you know you have been bitten by an infected tick?
The first signs of Lyme disease are often subtle and resemble those of other conditions. This can make a timely diagnosis quite difficult. The main symptoms are:
As the disease progresses and is left untreated, symptoms can become more severe and diverse, including:
Early diagnosis and treatment are therefore important to prevent the progression of Lyme disease and its more serious complications. So, consult your doctor if you suspect a tick bite particularly if you have been in areas known for tick activity.
How is Lyme disease diagnosed?

Diagnosing Lyme disease can be difficult. The “bull’s eye” lesion presents in a small percentage of cases, testing blood for the specific anti-bodies is at this point in time not very accurate, and the early symptoms “mimic” those of other diseases.
Doctors use a two-step method recommended by health experts to diagnose Lyme disease. First, they do a blood test to see if your body is reacting to the bacteria. If the first test is unclear or positive, they do a second, more specific test to confirm.
Early detection of Lyme disease is important, but it is not always easy. Sometimes the body has not yet produced enough antibodies to show up on a test. This can lead to a false negative result.
Because early blood tests can miss Lyme disease, doctors also look closely at your symptoms and whether you've been in areas where ticks live. A specific type of rash, known as erythema migrans, is a big clue, even if your blood test doesn't show Lyme disease.
What options are there after a diagnosis is confirmed?
So, there is actually only one option. The primary treatment for Lyme disease consists of antibiotics [4]:
As discussed, antibiotics are the first and only effective treatment for Lyme disease. But it doesn’t always have the required results for everyone, approximately 10-20% of treated patients experience persistent symptoms [5].
The medical community has long debated the existence of "chronic Lyme disease," or in medical terms referred to as Post Treatment Lyme Disease (PTLD). With PLTD, complaints such as fatigue and joint pain persist despite treatment.
This discussion went over the heads of those who were actually suffering. Fortunately, recent research [6] is shedding light on this condition, although the exact cause of PTLD is not yet fully understood, it is now believed to be due to a persistent immune response even after the infection has been treated.
These new insights could lead to recognition, deeper understanding and more advanced antibiotic treatments for people suffering from PTLD.

Years of medical denial of the chronic effects of Lyme disease and the pursuit of relief have led many to the path of alternative treatments. From therapies such as infrared sauna and acupuncture to dietary adjustments: Persons tailor the available methods to their unique needs and what suits their lifestyle.
This approach reflects the multifaceted nature of PTLD, where there is no one-size-fits-all solution. See for more detailed insights into alternative therapies for Lyme disease, the website of Colombia University, Lyme and Tick-Borne Diseases Center [7].
Like to learn more about the potency of IR saunas? Stay tuned.
The similarities in symptoms between Lyme disease after treatment and chronic fatigue syndrome (CFS) – a condition where the use of infrared sauna therapy for relief is supported by research – present the implicit helpfulness of this therapy for people with Lyme disease.
This evidence begs the question: Can infrared therapy be a valuable ally for those struggling with the lingering effects of Lyme? Before we get into this, let's first address three myths surrounding the use of IR saunas for Lyme disease.
There are claims that sauna heat can kill Lyme bacteria. This may stem from the idea that whole-body hyperthermia used in clinical settings substantially raises body temperature.
The gentle heat of infrared saunas, however, leads to mild whole body hyperthermia and cannot be compared to a medical treatment.
Lyme disease can cause sensitivity to sunlight. This is mainly due to ultraviolet radiation. However, infrared saunas do not emit ultraviolet light but a different light spectrum. This indicates that infrared saunas will not pose a risk in this regard.
It is generally believed that you should avoid saunas if you are taking antibiotics, due to the risk of reducing the effectiveness of the drug.
Although caution is advised when combining sauna use with antibiotic treatment, there is no direct contraindication. It has to do with a greater risk of overheating. It is therefore important to listen carefully to your body, hydrate sufficiently and plan shorter sessions.
We would like to emphasize that it is necessary to consult your doctor before trying any new alternative treatment.

Infrared saunas use infrared light to deliver heat directly to your body, reaching beneath the skin's surface in a way that traditional dry or steam saunas (which rely on heated air) can't match.
IR saunas operate at milder temperatures and provide a gentler, more bearable sauna experience, especially suitable when you find the intense heat of conventional saunas overwhelming.
Let's see how this heat, which feels like a light touch, from the IR sauna addresses the symptoms of PTLD.
For PTLD patients, the deep detoxification facilitated by infrared sauna therapy helps to alleviate the lingering effects of toxins that may contribute to ongoing symptoms such as fatigue and brain fog.
The far-reaching penetration of the infrared wavelengths causes a mild thermal response in the body, raising core temperature and activating the sweat glands.
Unlike superficial sweating, the sweat caused by infrared therapy is rich in toxins, including heavy metals and environmental pollutants, effectively removing them from the depths of the body.
As the body warms, blood vessels dilate, a process that improves circulation. This boost in blood flow accelerates the transport of oxygen and nutrients to the cells, which is essential for tissue repair and regeneration.
Improved circulation greatly aids people dealing with persistent Lyme symptoms by promoting tissue healing, potentially easing muscle and joint pain caused by the disease's long-term impacts.
At the same time, it facilitates the rapid removal of metabolic waste and toxins, optimizing the body's natural detoxification pathways.

The Best Infrared Sauna Blanket Reviews Of 2024
Infrared sauna therapy effectively targets inflammation, a major challenge in Lyme disease and particularly crucial for PTLD patients grappling with chronic inflammatory symptoms.
The increased circulation aids in the removal of inflammatory byproducts, providing relief from pain and discomfort while fostering an environment that supports the body's natural healing processes.
Infrared sauna sessions contribute to a better sleep by promoting profound relaxation and reducing stress levels. The gentle heat helps to balance the body's cortisol levels, the stress hormone, which can interfere with healthy sleep patterns.
As the body enters a state of relaxation, it becomes easier to fall asleep and stay asleep, leading to more restorative and rejuvenating sleep cycles.
For Lyme disease sufferers, who often experience sleep disturbances, this can mean a significant improvement in overall health and well-being.
The IR sauna heat creates a serene environment that naturally reduces stress and anxiety. An advantage that is especially relevant for persons living with the aftereffects of Lyme treatment.
Given their long-term symptom experience, finding effective stress management strategies is important, as stress can worsen symptoms and hinder the healing process.
Regular sauna sessions not only provide a mental and emotional break, but also help reduce stress-induced flare-ups of symptoms, contributing to a more balanced state of mind and facilitating recovery.

Strengthening the immune system is critical for individuals with PTLD as their bodies need to recover from the long-term effects of Lyme disease. The heat generated by the sauna mimics the body's natural mild fever response to infection, a basic defense mechanism.
This artificial fever can stimulate the immune system, making it better able to fight infections, including the bacteria responsible for Lyme disease.
Additionally, by reducing the body's toxic burden and relieving chronic stress, infrared sauna therapy can further support immune function, creating a stronger defense against disease.
Infrared sauna therapy actively uses the body's natural healing mechanisms. People with Lyme disease, who are often plagued by persistent symptoms and inflammation, can find relief and a path to improved well-being by using it as a complementary therapy on the road to recovery.
Realizing the full capacity of this therapy depends on consistency; regular sessions can optimize its therapeutic advantages.
The beauty of modern infrared sauna technology is its versatility and adaptability to individual lifestyles and preferences. Gone are the days when saunas were confined to the traditional cabin setup.
Today, a wide array of options ensures that there's a perfect fit for everyone.
When you have limited space, a minimalist lifestyle or a limited budget, sauna blankets offer a convincing solution. These handy blankets are not only affordable, but also easy to store and maintain, making them an excellent choice when you need a quick, accessible relaxation session.
However, if you prefer a more traditional sauna experience, a workout during your session and/or want to enjoy shared sessions with partner, family or friends, spacious infrared sauna cabins offer the perfect setting.
PEMF (Pulsed Electromagnetic Field) mats introduce an additional layer of therapy, combining the benefits of infrared heat with electromagnetic fields to support healing and wellness.
These mats are available in different sizes, making them versatile to use in chairs for a therapeutic session at work or even in your car seat so you can receive therapy on the go.
An investment in a sauna, whether it is a portable sauna blanket, a luxury cabin or a therapeutic PEMF mat, requires a well-considered decision.
We, at Saunace.com, are here to guide you in selecting the ideal infrared sauna solution that suits your needs and preferences. Based on our unbiased reviews and expert advice, you can trust us to help you find the perfect match.

During our search we came across the encouraging story of Therasage. The founders started from a personal battle against Lyme within their own family.
Their mission began with their daughter Julia's diagnosis, which prompted them to create products that meet the needs of people struggling with this condition. Visit Therasage for a closer look at how their experience has shaped their offering.
Saunace is supported by its audience. When you purchase through links on our website, we may earn an affiliate commission. Learn more.

Diane Sargent
Are you ready to explore your options and find the perfect infrared sauna match? Visit our blog at saunace.com for expert reviews and guides to help you choose the best fit for your wellness journey.
References
1. Alison W. Rebman and John N. Aucott, Post-treatment Lyme Disease as a Model for Persistent Symptoms in Lyme Disease, Frontiers in Medicine, https://www.ncbi.nlm.nih.gov/pmc/articles/PMC7052487/
2. Centers for Disease Control and Prevention, Lyme Disease, Data and Surveillance, https://www.cdc.gov/lyme/data-research/facts-stats/surveillance-data-1.html
3. Centers for Disease Control and Prevention, Lyme Disease, https://www.cdc.gov/lyme/index.html
4. Johns Hopkins Medicine Lyme Disease Research Center, Lyme Disease Treatment and Prognosis, https://www.hopkinslyme.org/lyme-disease/treatment-and-prognosis-of-lyme-disease
5. Yasir Alruwaili et al., Superior efficacy of combination antibiotic therapy versus monotherapy in a mouse model of Lyme disease, PubMed, https://pubmed.ncbi.nlm.nih.gov/38075920/
6. Simona Maksimyan et al., Post-Treatment Lyme Disease Syndrome: Need for Diagnosis and Treatment, Cureau, https://www.ncbi.nlm.nih.gov/pmc/articles/PMC8507427/
7. Colombia University, Lyme and Tick-Borne Diseases Center, Treatment Options Lyme Disease, https://www.columbia-lyme.org/treatment-options